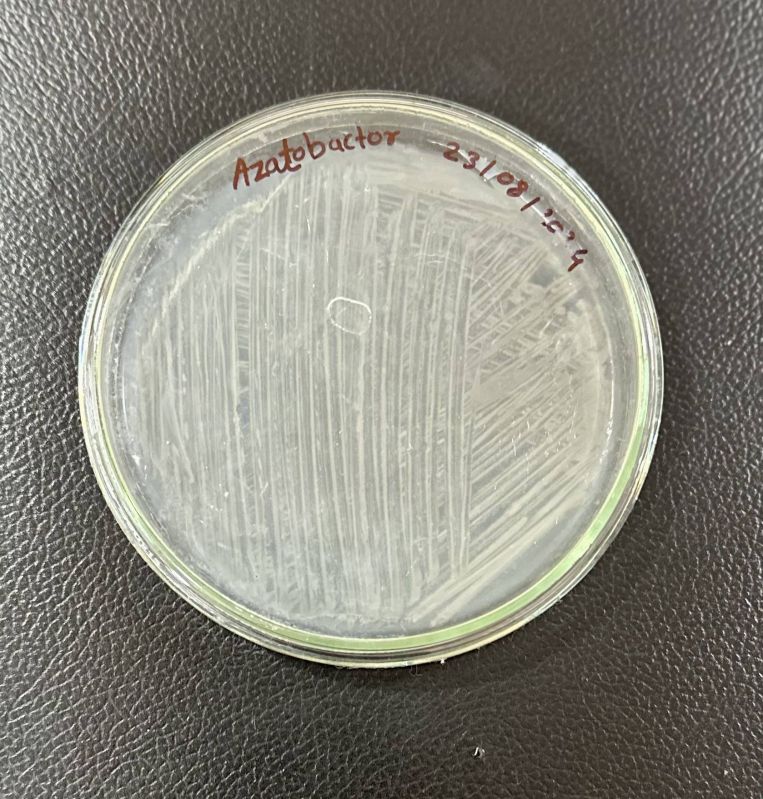
Azotobacter Biofertilizer

Company Information
Ask for more detail from the seller
Contact SupplierCarrier based | Powder, liquid, Granular |
Viable cell count | 1x 109 |
Target Use | Nitrogen Fixation |
Packing | 50kg,25 lit,250 lit |
Advantages:-
1) Azotobacter is a nitrogen-fixing bio-inoculants (20-40 kg N/ha).